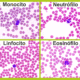
WBC - GLOBULOS BLANCOS

Edema agudo de pulmón servet urgencias veterinarias
Diagnóstico y tratamiento del edema pulmonar en servet urgencias veterinarias
El edema pulmonar ocurre cuando se acumula líquido en los pulmonares, esto dificulta la respiración. La presencia de liquido en los pulmones interfiere con el intercambio de gases y puede causa insuficiencia respiratoria.
El edema pulmonar puede ser agudo (inicio repentino) o crónico (que ocurre más lentamente con el tiempo). Si es agudo, se clasifica como una emergencia y el animal a de ser atendido con celeridad.
La causa más común del edema pulmonar detectado en Servet urgencias veterinarias es la insuficiencia cardíaca congestiva, habitual en animales ancianos donde el corazón no puede cumplir con las demandas del cuerpo.
El tratamiento inicial del edema pulmonar se enfoca en mejorar la función respiratoria y disminuir la cantidad de líquido presente en el pulmón. Generalmente incluye proporcionar oxígeno, diuréticos y en casos más graves ventilación asistida.
Los síntomas del edema agudo de pulmón son
Sensación de ahogo o dificultad para respirar (disnea) que empeora con la actividad o cuando el animal se tumba. Sibilancias, (silbidos que acompañan a la respiración) o jadeo para respirar. El animal suele manifestar ansiedad, inquietud o sensación de aprensión. Una tos que produce esputo espumoso que puede tener un color rosado y las mucosas teñidas de azul y para terminar latidos cardíacos rápidos e irregulares (palpitaciones)
Tratamiento
El Servet urgencias el edema pulmonar casi siempre se trata en la UCI. Al animal se le administra oxígeno a través de un helmet (casco que cubre toda cabeza) o se colocan pequeños tubos de plástico en la nariz. En casos más graves se puede colocar un tubo de respiración en la tráquea y conectarlo a un respirador si el animal no puede respirar bien por su cuenta.
La causa del edema debe identificarse y tratarse rápidamente.
Los medicamentos que pueden usarse incluyen:
Diuréticos que eliminan el exceso de líquido del cuerpo.
Medicamentos que fortalecen el músculo cardíaco, controlan los latidos del corazón o alivian la presión sobre el corazón.
Otros medicamentos cuando la insuficiencia cardíaca no es la causa del edema pulmonar